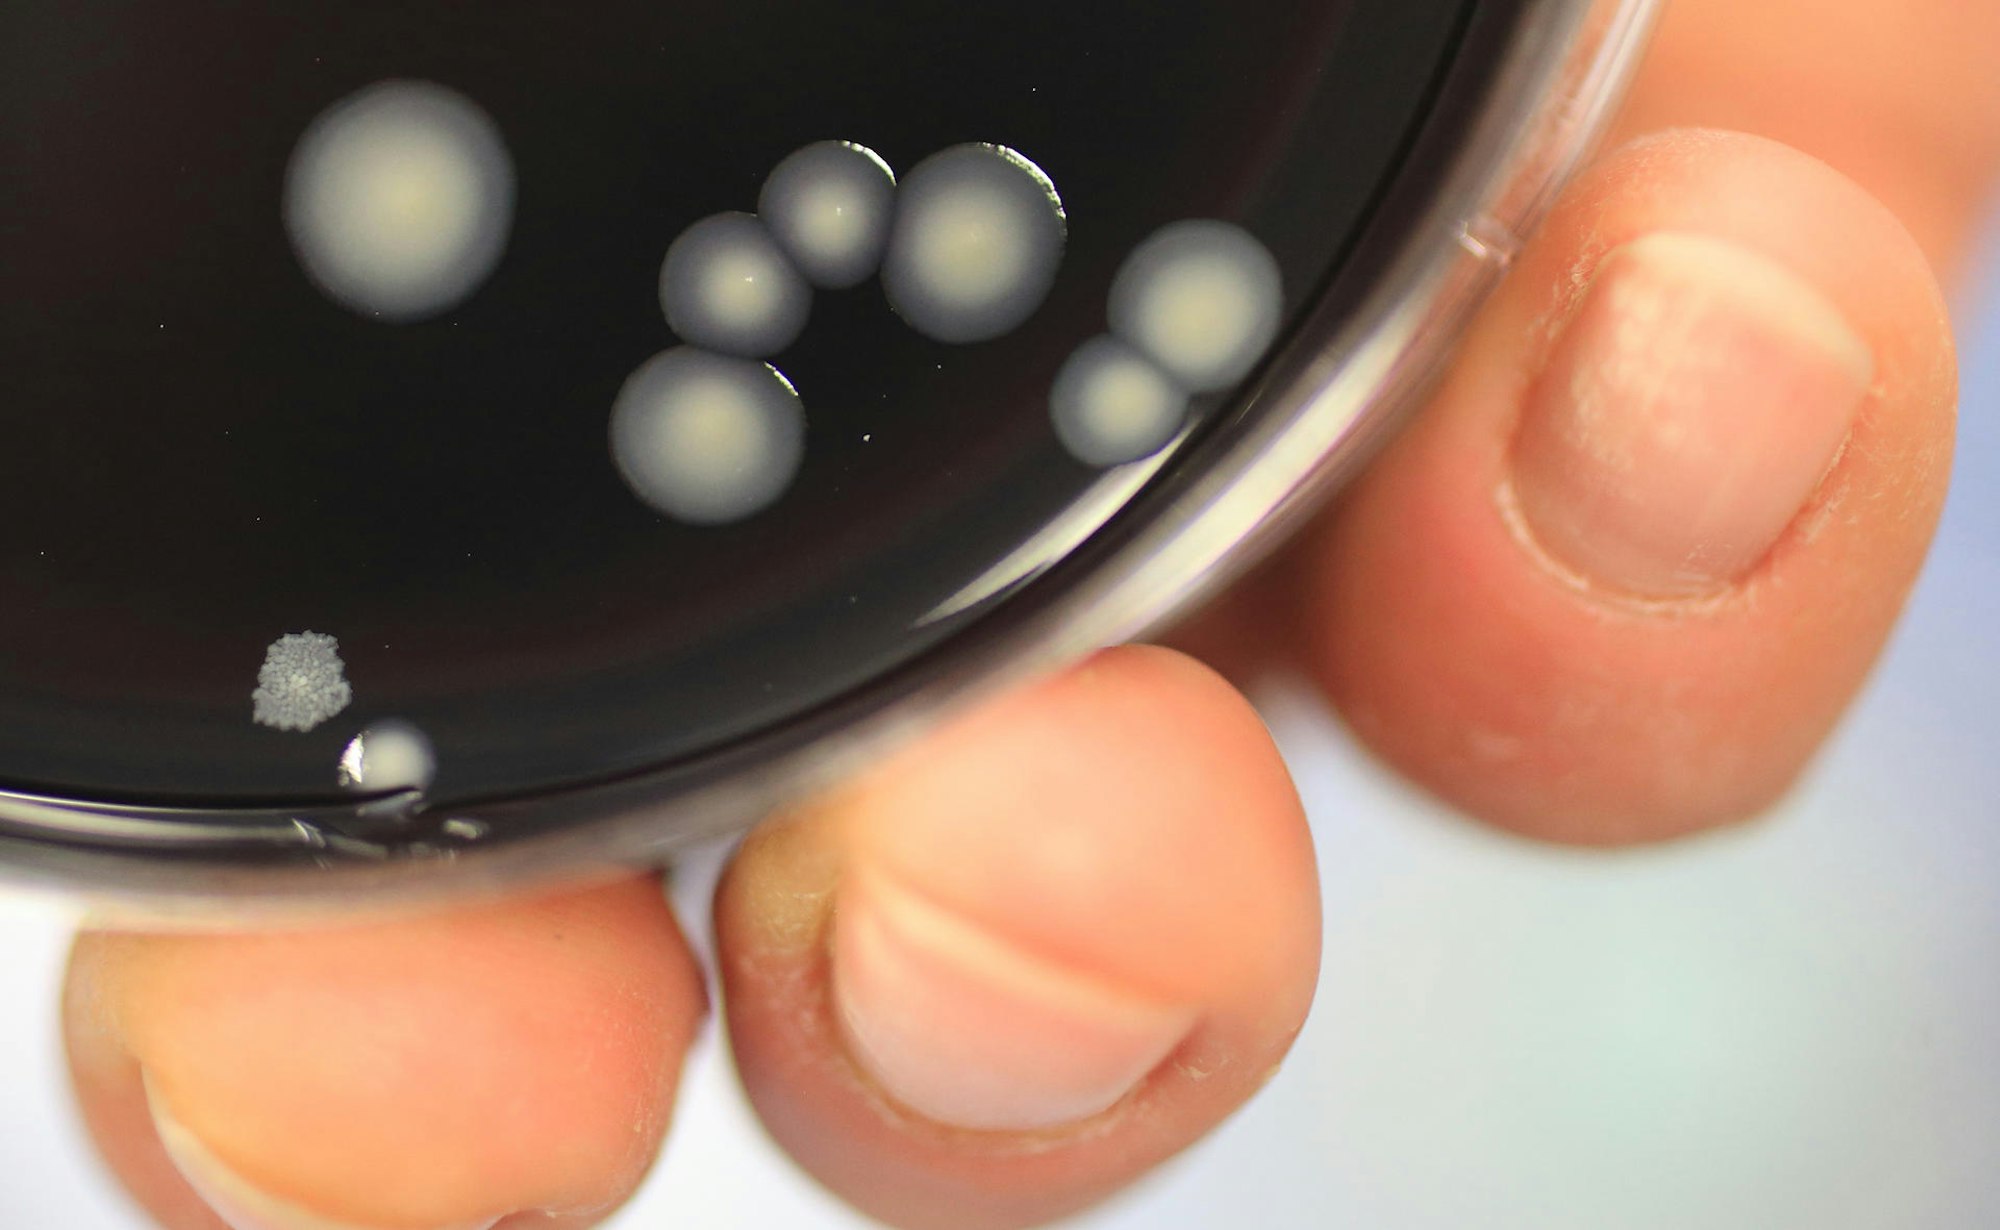
Neuer Inhalt

Kiel – Wer lange nicht die Wasserhähne aufgedreht hat, sollte das bei der Rückkehr aus dem Urlaub direkt tun – und nicht erst mal einen Schluck davon trinken oder direkt duschen. Denn in den Wasserleitungen könnten sich Bakterien vermehrt haben – das ist eine Gefahr für die Gesundheit.
Stattdessen sollte man erst einmal das Wasser an allen Zapfstellen etwas laufen lassen, bevor man es nutzt, rät das Institut für Schadenverhütung und Schadenforschung der öffentlichen Versicherer (IFS). In einem durchschnittlichen Einfamilienhaus genügt es, etwa zehn Liter ablaufen zu lassen, um das Wasser auszutauschen, das während der Abwesenheit in den Rohren gestanden hat.
Legionellen können eine Lungenentzündung mit Husten, Fieber, Schüttelfrost und Verwirrtheitszuständen verursachen – die sogenannte Legionärskrankheit,
Copyright: Jens Wolf/dpa-Zentralbild/dpa-tm
Ab 25 Grad fühlen sich die Bakterien richtig wohl
Legionellen vermehren sich bei Temperaturen zwischen 25 und 55 Grad Celsius. Gerade in stehendem Wasser kann es zu einer erhöhten Konzentration der Bakterien kommen. In belasteten Anlagen können sich Menschen zum Beispiel beim Duschen oder Reinigen am Waschbecken infizieren, indem sie feinste Wassertröpfchen einatmen.
Die Ansteckungsgefahr beim Trinken von belastetem Wasser ist geringer, aber ausgeschlossen ist eine Infektion nicht. Das Wasser müsste beim Verschlucken versehentlich über die Luftröhre in die Lunge gelangen, so die Bundeszentrale für gesundheitliche Aufklärung (BZgA).
Das könnte Sie auch interessieren:
Lungenentzündung und Verwirrtheitszustände: Die Legionärskrankheit
Eine Infektion äußert sich als eine Form von Lungenentzündung mit Husten, Schüttelfrost, Kopfschmerzen, schwerem Krankheitsgefühl und hohem Fieber. Auch Durchfall oder Verwirrtheitszustände sind möglich. Man spricht dabei von der Legionärskrankheit oder Legionellen-Pneumonie. Wird diese nicht oder falsch behandelt, verläuft die Lungenentzündung häufig schwer. Bei korrekter Behandlung bestehen gute Heilungsaussichten, so die BZgA.
Das Pontiac-Fieber kann ebenfalls durch Legionellen verursacht werden, mit grippeähnlichen Beschwerden wie Fieber, Unwohlsein, Kopf- und Gliederschmerzen, aber nicht in einer Lungenentzündung. Diese Erkrankung heilt meist von selbst innerhalb einer Woche aus.
Tipp für Haussitter: Gießwasser aus dem Badezimmer-Hahn

Bei der Pflanzenversorgung während des Urlaubs können Nachbarn und Freunde das Legionellenwachstum reduzieren.
Copyright: Christin Klose/picture alliance / dpa Themendienst
Einen weiteren Tipp zur Vermeidung solcher Infektionen hat das IFS noch für alle Haussitter – also für Nachbarn, Verwandte und Freunde, die während des Abwesenheit der Bewohner das Haus in der Zeit betreuen und die Pflanzen gießen. Sie sollten Wasser an einer Zapfstelle abfüllen, die weit von der Hauptwasserversorgung entfernt liegt. Dadurch wird das Wasser in einem großen Bereich der Versorgungsleitungen immer wieder bewegt – was das Wachstum der Legionellen unterbinden kann.
Bei einem Einfamilienhaus ist das zum Beispiel meist das Badezimmer im obersten Stockwerk. (dpa/tmn)

